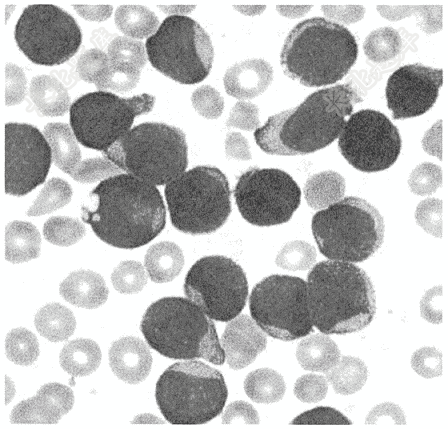

试题详情
- 简答题患儿,4岁,外周血图片如下,请问患者诊断考虑为
关注下方微信公众号,搜题查看答案

热门试题
- 患者女性,72岁,间歇性跛行1年余。行下
- 下列心电图检查最可能的是( )
- 女性,47岁,腹部不适( ) <
- 患者女,β-hCG水平达80000U/L
- 女,62岁,以“突发胸痛伴恶性、呕吐7小
- 患者男性,40岁,体检查心电图如下:
- 男性,45岁,右大腿外伤1小时来诊,查X
- 患者,女性,38岁,乏力、纳差两月。请结
- 男性患者,因体检胸片发现右下肺病变入院,
- 女,36岁。因“易饥多食伴消瘦2月”来诊
- 女,63岁,双膝活动后疼痛,有响声3年,
- 男,59岁,以“间断胸闷、心慌1年余”为
- 患者男性,48岁。反复呕血半年就诊。食管
- 请选出正确诊断( )
- 女性,25岁,肠吻合术后22年,腹痛发热
- 选择正确诊断( )
- 请选出正确诊断( )
- 患者男性,68岁。肛门坠胀、腹泻2月就诊
- 患者女性,34岁。摔伤致右手疼痛2小时。
- 男,55岁。近1月来出现肝区疼痛、腹胀,